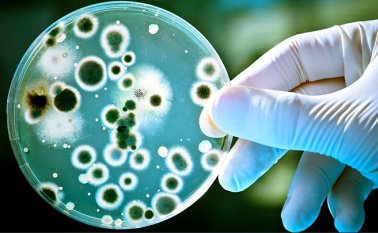
Según un amplio estudio publicado esta semana. Internet

Artículo
Pese a vacunación, no habrá inmunidad de rebaño: OMS
El mercado Huanan de Wuhan, considerado como el primer gran foco de la epidemia, fue cerrado el 1 de enero de 2020.
Vida y salud
Vida y saludArtículo
'Sistema de salud no está preparado para la pandemia': abogado de PCR
Alberto González Mebarack, a través de una tutela, reactivó solicitud de pruebas COVID-19.
Vida y salud
Vida y saludArtículo
"Es un llamado preciso para que sigamos las medidas de bioseguridad"
Mónica Rojas, Jefe de Enfermería, habla sobre su experiencia en medio de un nuevo episodio de contagios de COVID-19.
Publicidad
Seguir leyendo
Publicidad
Publicidad
Más noticias
Artículo
Vida y salud
Vida y saludConozca qué es y cómo prevenir el síndrome de ovarios poliquísticos
Artículo
Vida y salud
Vida y saludMalnutrición, mal que persiste y afecta a millones en América Latina
Publicidad